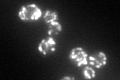
YDR148C

View description
Dihydrolipoyl transsuccinylase, component of the mitochondrial alpha-ketoglutarate dehydrogenase complex, which catalyzes the oxidative decarboxylation of alpha-ketoglutarate to succinyl-CoA in the TCA cycle; phosphorylated
Localization:
Intensity:
Fold change:
Significance:
-
C’ GFP library in SD

mitochondria56.59 -
N' NOP1pr-GFP in SD

mitochondria172.899 -
N' TEF2pr-mCherry in SD

mitochondria347.185 -
N' NATIVEpr-GFP in SD

mitochondria34.2486 -
N' TEF2pr-VC and Cyto-VN in SD

#N/A0 -
C’ GFP library in SD+DTT
mitochondria81.231.43Yes -
C’ GFP library in SD+H2O2

mitochondria54.620.96No -
C’ GFP library in Starvation Media

mitochondria100.991.78Yes -
C’ GFP library on the background of Pup2-DaMP

mitochondria -
C’ GFP library on the background of CCT mutant

mitochondria75.79091.33888Yes
